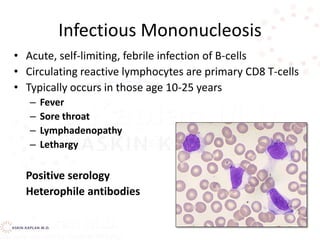
Infectious Mononucleosis
• Acute, self-limiting, febrile infection of B-cells
• Circulating reactive lymphocytes are primary CD8 T-cells
• Typically occurs in those age 10-25 years
– Fever
– Sore throat
– Lymphadenopathy
– Lethargy
Positive serology
Heterophile antibodies
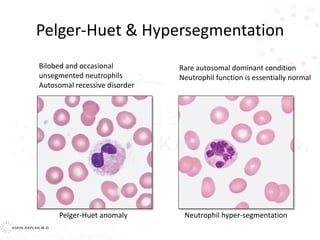
Pelger-Huet & Hypersegmentation
Bilobed and occasional
unsegmented neutrophils
Autosomal recessive disorder
Rare autosomal dominant condition
Neutrophil function is essentially normal
Pelger-Huet anomaly Neutrophil hyper-segmentation
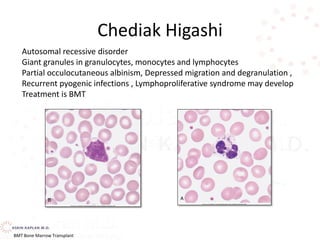
Chediak Higashi
Autosomal recessive disorder
Giant granules in granulocytes, monocytes and lymphocytes
Partial occulocutaneous albinism, Depressed migration and degranulation ,
Recurrent pyogenic infections , Lymphoproliferative syndrome may develop
Treatment is BMT
BMT Bone Marrow Transplant
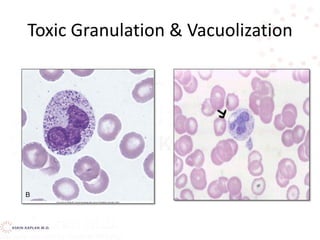
Toxic Granulation & Vacuolization

This document discusses leukocyte disorders, which can be either malignant (tumors) or non-malignant. It focuses on non-malignant disorders affecting neutrophils. Neutrophils and other leukocytes are produced through hematopoiesis in the bone marrow from stem cells. The document describes the different types of leukocytes (neutrophils, eosinophils, basophils, monocytes, lymphocytes), their functions, and normal ranges. It also discusses disorders characterized by increased or decreased levels of these cells.






















![Monocytes
• Monocytes in the circulation are precursors to tissue
macrophages.
• Monocytes migrate into tissues, where over about 8 h,
they develop into macrophages under the influence of
macrophage colony-stimulating factor (M-CSF),
secreted by various cell types (eg, endothelial cells,
fibroblasts).
• At infection sites, activated T cells secrete cytokines
(eg, interferon-gamma [IFN-gamma]) that induce
production of macrophage migration inhibitory factor,
preventing macrophages from leaving.](https://image.slidesharecdn.com/leukocytedisordersakk-191124221759/85/Leukocyte-disorders-akk-23-320.jpg)













![Monocytosis
Monocytosis Absolute count >0.8 x 109/L
Most commonly seen in conditions with increased
cell damage:
– Chronic infection [TB, syphilis, protozoal infections,
rickettsial infections]
– Recovery from agranulocytosis
– Post-splenectomy
– Strenuous exercise
– Subacute bacterial endocarditis](https://image.slidesharecdn.com/leukocytedisordersakk-191124221759/85/Leukocyte-disorders-akk-37-320.jpg)
![Lymphocytosis
Lymphocytosis Absolute count >5.5 x 109/L
Normally:
– 60-80% circulating lymphs are T-cells
– [2:1 CD4/CD8]
– 10-20% are B-lymphs
– 5-10% are natural killer or NK cells
Infections
Viral
Infectious mononucleosis
Bacterial
Pertussis
Thyrotoxicosis
Recovery from acute infections
Neoplasm
Leukemias
Lymphomas
Causes](https://image.slidesharecdn.com/leukocytedisordersakk-191124221759/85/Leukocyte-disorders-akk-38-320.jpg)

![Neutropenia Causes
• Defects inside or outside the Bone Marrow
– Decreased proliferation [failure of cells - aplasia]
– Decreased maturation [insufficient number of
precursors undergoing abnormal maturation]
– Decreased survival [increased destruction and/or
rapid removal of cells]
– Distribution [total body pools are normal,
circulating numbers are reduced]](https://image.slidesharecdn.com/leukocytedisordersakk-191124221759/85/Leukocyte-disorders-akk-46-320.jpg)






![Pelger Huet vs band neutrophil
•Pelger Huet – an inherited condition
resulting in hyposegmentation of
granulocyte nuclei with increased density
and coarseness of the chromatin.. Don’t
confuse this anomaly with a neutrophilic
left shift!
•May-Hegglin - a rare syndrome
characterized by leukopenia, variable
thrombocytopenia, GIANT PLATELETS, and
gray-blue cytoplasmic inclusions in the
neutrophils and monocytes [dohle-like
bodies]](https://image.slidesharecdn.com/leukocytedisordersakk-191124221759/85/Leukocyte-disorders-akk-53-320.jpg)

![Decreased production
Drug-induced—alkylating agents (nitrogen mustard, busulfan, chlorambucil, cyclophosphamide); antimetabolites
(methotrexate, 6-mercaptopurine, 5-flucytosine); noncytotoxic agents [antibiotics (chloramphenicol, penicillins,
sulfonamides), phenothiazines, tranquilizers (meprobamate), anticonvulsants (carbamazepine),
antipsychotics (clozapine), certain diuretics, anti-inflammatory agents, antithyroid drugs, many others]
Hematologic diseases—idiopathic, cyclic neutropenia, Chédiak-Higashi syndrome, aplastic anemia, infantile
genetic disorders, Tumor invasion, myelofibrosis
Nutritional deficiency—vitamin B12, folate (especially alcoholics)
Infection—tuberculosis, typhoid fever, brucellosis, tularemia, measles, infectious mononucleosis, malaria, viral
hepatitis, leishmaniasis, AIDS
Peripheral destruction
Antineutrophil antibodies and/or splenic or lung trapping
Autoimmune disorders—Felty’s syndrome, rheumatoid
arthritis, lupus erythematosus
Drugs as haptens—aminopyrine, α-methyldopa,
phenylbutazone, mercurial diuretics, some
phenothiazines
Wegener’s granulomatosis
Peripheral pooling (transient neutropenia)
Overwhelming bacterial infection (acute endotoxemia)
Hemodialysis
Cardiopulmonary bypass
CAUSES OF LEUKOPENIA](https://image.slidesharecdn.com/leukocytedisordersakk-191124221759/85/Leukocyte-disorders-akk-97-320.jpg)